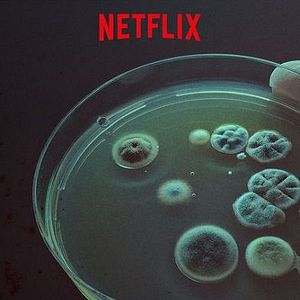
Foto Aquejados

Serie documental que explora las vidas de siete pacientes que sufren enfermedades crónicas no reconocidas por la medicina tradicional. Día a día, cada uno de ellos se enfrentan a desconcertantes síntomas, diagnósticos inesperados y costosos tratamientos, que evitan puedan ser un miembro activo de la sociedad. De la mano del director Dan Partland, conoceremos a fondo cada una de las historias de los pacientes que dicen ser sensibles a la electricidad, sufrir del síndrome de fatiga crónica, encefalomielitis mialgia o la enfermedad de Hashimoto. En cada episodio, se reúnen los testimonios de aquejado, testigos y expertos sobre el tema para intentar explicar el origen de las extrañas enfermedades. ‘Aquejados’ es una producción original de Netflix que fue lanzada en la plataforma el 10 de agosto de 2018.
 0:50
0:50